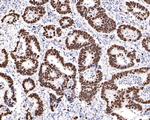
Ki-67 Antibody in Immunohistochemistry (Paraffin) (IHC (P))

Search
Invitrogen
Ki-67 Recombinant Rabbit Monoclonal Antibody (SR00-02)
{{$productOrderCtrl.translations['antibody.pdp.commerceCard.promotion.promotions']}}
{{$productOrderCtrl.translations['antibody.pdp.commerceCard.promotion.viewpromo']}}
{{$productOrderCtrl.translations['antibody.pdp.commerceCard.promotion.promocode']}}: {{promo.promoCode}} {{promo.promoTitle}} {{promo.promoDescription}}. {{$productOrderCtrl.translations['antibody.pdp.commerceCard.promotion.learnmore']}}
图: 1 / 10
Ki-67 Antibody (MA5-50664) in IHC (P)

Please note: We are reviewing Western blot images included in the antibody testing data in our catalog, including those provided by third parties. Unless expressly labeled or annotated as “raw-unedited”, Western blot images included in the antibody testing data in our catalog may have been edited, optimized or otherwise adjusted for presentation.
产品信息
MA5-50664
种属反应
宿主/亚型
Expression System
分类
类型
克隆号
抗原
偶联物
形式
浓度
规格
纯化类型
保存液
内含物
保存条件
运输条件
RRID
产品详细信息
Positive control: Human tonsil tissue, human lymph nodes tissue, human cervical carcinoma tissue, human colon carcinoma tissue, mouse spleen tissue, mouse intestinal tissue, mouse ovary tissue, rat thymus tissue, human gastric cancer.
Predicted band size: 345-395 kDa
Subcellular Location: Nucleus, Chromosome.
Not suitable for Mouse in Immunofluorescence.
靶标信息
Ki-67 is a nuclear protein that is expressed during various stages in the cell cycle, particularly during late G1, S, G2, and M phases. The protein has a forkhead associated domain (FHA) through which it associates with euchromatin at the perichromosomal layer, the centromeric heterochromatin, and the nucleolus. Ki-67 is shown to have a cell cycle dependent topographical distribution with perinucleolar expression at G1, expression in the nuclear matrix at G2, and expression on the chromosomes during M phase. Ki-67 is commonly used as a proliferation marker because it is not detected in G0 cells, but increases steadily from G1 through mitosis. Ki-67 antibodies are useful in establishing the cell growing fraction in neoplasms. In neoplastic tissues, the prognostic value is comparable to the tritiated thymidine-labelling index. The correlation between low Ki-67 index and histologically low-grade tumors is strong. Ki-67 is routinely used as a neuronal marker of cell cycling and proliferation.
仅用于科研。不用于诊断过程。未经明确授权不得转售。
篇参考文献 (0)
生物信息学
蛋白别名: Antigen identified by monoclonal antibody Ki-67; Antigen identified by monoclonal antibody Ki-67 homolog; Antigen KI-67; Antigen KI-67 homolog; Proliferation marker protein Ki-67; RP11-380J17.2
基因别名: D630048A14Rik; Ki-67; Ki67; MKI67
UniProt ID: (Mouse) E9PVX6
Entrez Gene ID: (Rat) 291234, (Mouse) 17345




